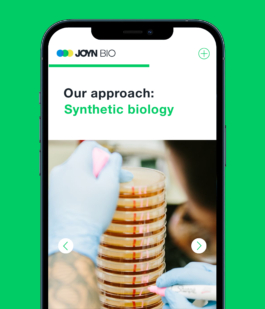
Studio Annette Fischer

x Joyn Bio

Joyn Bio is a Boston-based, bio-tech venture from Leaps by Bayer that focuses on new sustainable agriculture solutions. To begin Joyn Bios development of their brand system, expert interviews and design/brand workshops with an accompanying catalogue were conducted in advance by Circle Culture Consulting and served as a basis for the visual approach. Along with the design of their logo and website including illustrations, I provided art direction for the on-location photo shoot at Joyn Bio’s Boston-based labs and created a still life with their lab equipment for a unique imagery on their company`s website.
Client: Circle Culture Consulting
Photography: Gene Glover
Coding: HHey
Year: 2018
Branding
Corporate Identity
Stationary
UI / Webdesign
Website Programming
Illustration
Foto Shooting
Product Still Styling


















More Projects
x Joyn Bio

Joyn Bio is a Boston-based, bio-tech venture from Leaps by Bayer that focuses on new sustainable agriculture solutions. To begin Joyn Bios development of their brand system, expert interviews and design/brand workshops with an accompanying catalogue were conducted in advance by Circle Culture Consulting and served as a basis for the visual approach. Along with the design of their logo and website including illustrations, I provided art direction for the on-location photo shoot at Joyn Bio’s Boston-based labs and created a still life with their lab equipment for a unique imagery on their company`s website.
Branding
Corporate Identity
Stationary
UI / Webdesign
Website Programming
Illustration
Foto Shooting
Product Still Styling
Client: Circle Culture Consulting
Photography: Gene Glover
Coding: HHey
Year: 2018

More Projects
| Cookie | Dauer | Beschreibung |
|---|---|---|
| cookielawinfo-checkbox-analytics | 11 months | This cookie is set by GDPR Cookie Consent plugin. The cookie is used to store the user consent for the cookies in the category "Analytics". |
| cookielawinfo-checkbox-functional | 11 months | The cookie is set by GDPR cookie consent to record the user consent for the cookies in the category "Functional". |
| cookielawinfo-checkbox-necessary | 11 months | This cookie is set by GDPR Cookie Consent plugin. The cookies is used to store the user consent for the cookies in the category "Necessary". |
| cookielawinfo-checkbox-others | 11 months | This cookie is set by GDPR Cookie Consent plugin. The cookie is used to store the user consent for the cookies in the category "Other. |
| cookielawinfo-checkbox-performance | 11 months | This cookie is set by GDPR Cookie Consent plugin. The cookie is used to store the user consent for the cookies in the category "Performance". |
| viewed_cookie_policy | 11 months | The cookie is set by the GDPR Cookie Consent plugin and is used to store whether or not user has consented to the use of cookies. It does not store any personal data. |